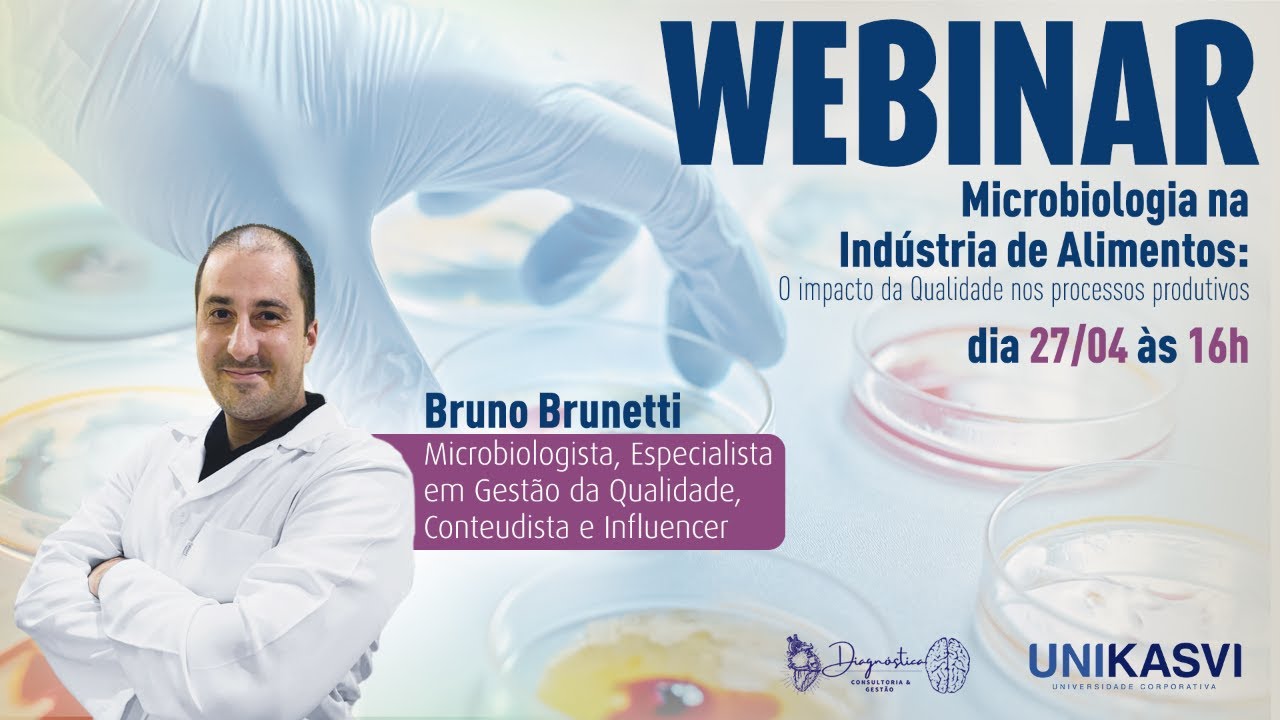
Microbiologia na Indústria de Alimentos: O impacto da Qualidade nos processos produtivos

[Música] relembre uma memória marcante Pronto agora tente lembrar o que você almoçou três semanas atrás essa segunda memória provavelmente não é tão forte mas por que não porque Lembramos de algumas coisas e de outras não E porque as memórias desaparecem vamos ver primeiro como as memórias se formam Quando você vive algo como desar o número de telefone essa experiência é convertida em um impulso de energia elétrica que percorre uma rede de neurônios a informação chega primeiramente na memória de curto prazo Onde fica disponível de alguns segundos até poucos minutos é então transferida para memória de
longo prazo através de áreas como o hipocampo e finalmente até várias regiões de armazenamento no cérebro os neurônios do cérebro interagem entre si através de sítios de comunicação chamad das sinapses usando neurotransmissores especializados se dois neurônios comunicam-se repetidamente uma coisa notável acontece a eficiência da comunicação entre os dois aumenta esse processo chamado de potenciação de longa duração é considerado mecanismo através do qual as memórias são armazenadas a longo prazo Mas como as perdemos a idade é um fator conforme envelhecemos as sinapses começam a vacilar e a enfraquecer afetando a capacidade de recuperarmos As Memórias os
cientistas têm várias teorias sobre o que está por trás dessa deterioração do encolhimento Comum do cérebro no qual hipocampo perde 5% de seus neurônios a cada década para uma perda total de 20% até aos 80 anos de idade a queda na produção de neurotransmissores como acetilcolina que é vital para a memória e o aprendizado essas mudanças parecem afetar a forma como as pessoas recuperam as informações a idade também afeta a nossa capacidade de criar memórias As Memórias são adquiridas mais facilmente quando estamos prestando atenção quando estamos profundamente concentrados e quando são significativas para nós problemas
físicos e mentais que tendem a aumentar conforme envelhecemos interferem na nossa capacidade de prestar atenção e assim agem como ladrões de memórias outra causa que leva a problemas de saúde é o estresse crônico quando somos constantemente sobrecarregados com responsabilidad do trabalho ou pessoais o nosso corpo fica hiperalerta essa é uma reação de mecanismo fisiológico desenvolvido para termos certeza de que podemos sobreviver em uma crise os químicos do stresse ajudam a mobilizar energia e a aumentar o estado de alerta no entanto com stress crônico o corpo fica cheio desses químicos resultando de uma perda de células
cerebrais e na incapacidade de formar outras novas o que afeta a nossa capacidade de reter novas informações a depressão É Outro fator pessoas que são depressivas têm 40% mais chance de desenvolver problemas de memória níveis baixos de serotonina um neurotransmissor associado à excitação podem deixar indivíduos depressivos menos atentos a novas informações o apego a tristes eventos no passado outro sintoma da depressão dificulta a concentração no presente afetando a habilidade de reter Memórias de curto prazo O isolamento que é vinculado a depressão é outro ladrão de memória um estudo revelou que pessoas idosas com altos níveis
de Integração Social tiveram uma taxa menor na perda de memória durante um período de 6 anos o motivo exato É ainda desconhecido mas especialist suspeitam que interações sociais dão ao nosso cérebro um exercício mental assim como a força muscular nós precisamos usar o nosso cérebro ou arriscamos perdê-lo mas não se desespere Existem várias precauções que você pode tomar para ajudar o seu cérebro na preservação das memórias certifique-se de que esteja fisicamente ativo aumentar a circulação para o cérebro faz bem e coma bem seu cérebro precisa de todos os nutrientes essenciais para funcionar corretamente e finalmente
dê a ele um exercício expor o cérebro a desafio como aprender o novo idioma é uma das melhores defesas para manter o seu cérebro intacto